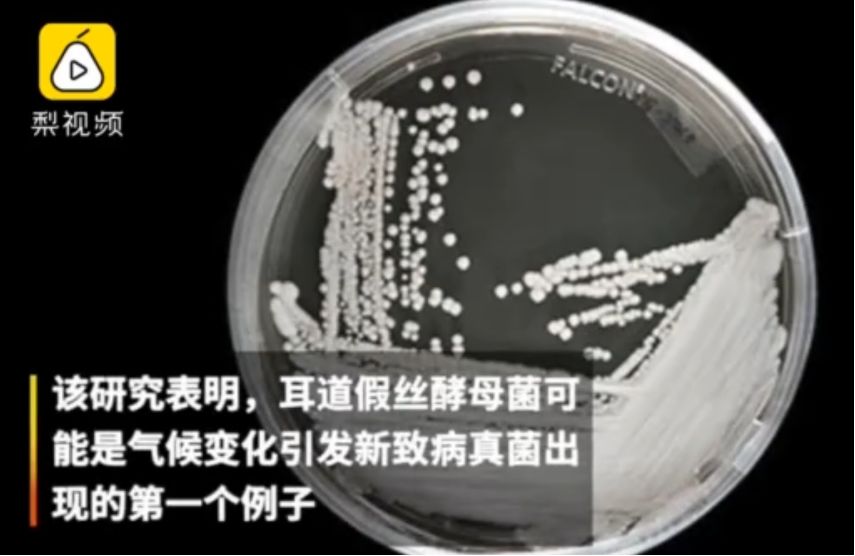
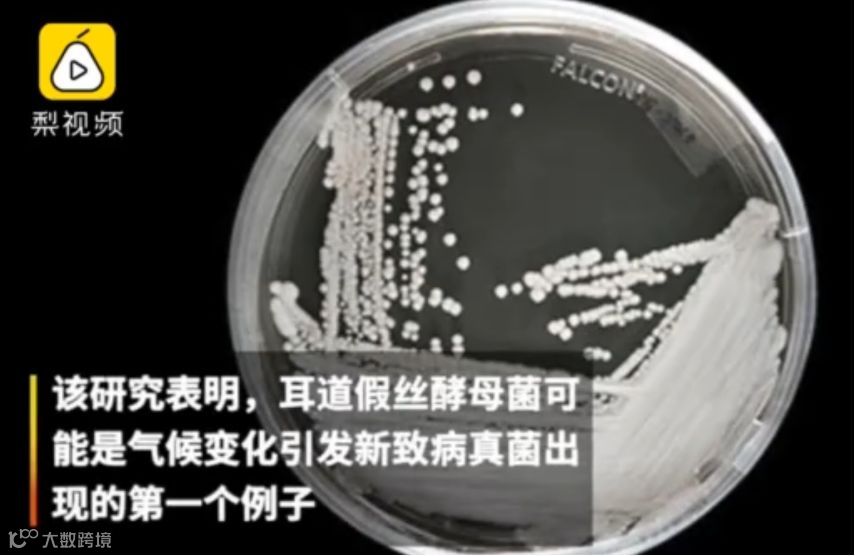

每天3分钟,速览全国法治新闻
8月6日星期二,农历七月初六
封面新闻

1、林郑月娥:5日上午在记者会上表示,近期香港发生的一连串极端暴力行为,正将香港推向十分危险的境地。她呼吁各界冷静地想一想,是否要押上香港七百多万人的稳定生活和未来作赌注。(央视新闻)
2、香港警方:5日下午举行新闻发布会表示,针对以表达诉求为名的激进示威活动涉及的公然违法、肆意破坏社会安宁、暴力冲击警方等行为,从6月9日至8月5日早上,警方共拘捕420人,年龄在14至76岁之间,涉及非法集结、袭警、暴动罪等。(中国新闻网客户端)
3、发改委、商务部:6日称,由于日前美方宣称拟对3000亿美元中国输美商品加征10%关税,严重违背中美两国元首大阪会晤共识,国务院关税税则委员会对3日后新成交的美国农产品采购暂不排除进口加征关税,中国相关企业已暂停采购美国农产品。(央视新闻)
4、住建部、财政部、国务院扶贫办:日前发布通知指出,全国现有4类重点对象危房存量135.2万户,已全部纳入2019年中央农村危房改造任务和补助资金范围,须于2019年底前全部开工,2020年6月底前全部竣工。(中国新闻网)
5、人社部:从今年下半年开始,明确将社会保障卡作为全国专业技术人员资格考试报名和进入考场的有效身份证件。有条件的地区可结合当地电子社会保障卡应用,为报考人员提供更加高效便捷的服务。(@中国新闻社)
6、央行:就今日人民币对美元汇率突破7元一事表示,这个“7”不是年龄,也不是堤坝,更像水库的水位,丰水期的时候高一些,到了枯水期的时候又会降下来,有涨有落,都是正常的。人民币汇率完全能够在合理均衡水平上保持基本稳定。(@人民日报)
7、市场监管总局等多部门:5日在国务院政策例行吹风会表示,将进一步加强违规涉企收费治理,加大对行业协会商会、行政机关下属单位、中介机构等方面的收费监管力度,坚决查处一批典型案例。(央视新闻)
8、湖北恩施鹤峰县躲避峡山洪暴发 多人被困。目前已有61人获救,另有12人遇难、1人失联,救援人员正在进行拉网式排查。(央视新闻)
1、警方通报男子被狗袭击身亡 4日,广东广州,一名电工回公司加班工作时,遭公司内3条罗威纳犬袭击死亡。广州警方5日通报:该公司法人代表及负责管理饲养犬只者,涉嫌过失致人死亡罪被刑拘;涉事的3条犬只已被隔离控制,案件正进一步调查中。(@广州警方)

2、上海宝马车司机醉驾撞人致2死 3日,上海一男子醉驾宝马车,先后撞上两辆电瓶车及一位行人,该男子行至沪闵路时发生单车事故,被警方抓获。事故造成2人死亡,1人受伤。金某逃逸被抓时还在车内昏睡,目前已被依法刑拘。(@新京报我们视频)

3、徐州一教师发文称遭不公对待,官方5日公布调查进展 经调查,城东派出所在对李秀娟传唤、审查过程中,未发现有对其殴打、辱骂行为。下一步,联合调查组将对李秀娟反映执法民警对其殴打、辱骂行为进行深入调查,根据调查结果,依法依规处理。4日,教师李秀娟在网络发帖,反映其遭受不公正待遇并声称准备轻生,引起社会各界关注。(央视新闻)

4、男子在朋友圈骂人被罚1000元,法官:名誉侵权!柳某与皮某是微信好友。今年1月,皮某在微信朋友圈称柳某破坏别人的家庭,并配以侮辱性词汇和柳某照片。近日,柳某诉至重庆合川法院。法院经审理认为,皮某的行为已构成名誉侵权行为,判决皮某立即删除微信朋友圈中所发布针对柳某的不当言论,并赔偿柳某精神损害抚慰金1000元,同时在微信朋友圈中发表道歉声明。(法制日报)

5、气候变暖或致超级真菌出现 美国微生物学会期刊《mBio》7月的研究指出,因多重耐药和致死率高的特性,被称为“超级真菌”的耳道假丝酵母菌可能是首例气候变化引发出现的新致病真菌。随着全球变暖,真菌已开始适应更高的温度环境,真菌疾病有可能在21世纪不断扩大。(@梨视频)
6、成都一汽车起火并发生燃爆,现场浓烟滚滚 5日13时左右,在四川成都成渝立交一汽车起火后发生燃爆,现场浓烟滚滚,并有巨大声响。据成都警方通报,目前大火被扑灭,司机被控制,事故未造成人员伤亡。(央视新闻)

1、男子潜逃14年,被抓后向民警推销产品 近日,重庆渝北警方抓获上海逃犯孙某,他14年前因沉迷赌博,挪用50余万公款,后潜逃至重庆。审讯时,孙某对犯罪事实供认不讳,问及以前的工作,反而露出会心的笑容,向民警打起了广告。(@梨视频)

2、巴西黑帮头目戴硅胶面具,假扮女儿越狱 4日,巴西一所监狱的黑帮头目试图越狱,他戴着硅胶面具和假发,身穿卡通T恤,扮成前来探监的女儿。由于紧张,他在走出监狱前被狱警识破。据悉,他的刑期有73年。(@梨视频)

1、夫妻纠纷丈夫拿刀砍人,事出紧急民警徒手夺刀 近日,江苏无锡安镇派出所接报警称某小区内有人家暴,妻子躲进邻居家喊救命。民警冯介红立即出警。冯介红在了解情况时,一名纹身男子突然持刀冲到门口辱骂,情况危急,他随即徒手夺刀并控制住男子。目前,该男子已被行政拘留。(@中国警方在线)

2、公交司机被大爷骂,女孩递纸条安慰 近日,山东济南一老汉和一小姑娘上车,公交车司机好心提醒门即将关闭,引起老汉不满,一直指责司机,司机无奈道歉。这一切都被坐在后排的一女孩看在眼里。当两人下车后,女孩给司机一张纸条,上面写着:“你辛苦了老师,请别生气。”(@梨视频)

3、90后护士送病人途中晕倒,醒后第一句话让人心疼 湖北省第三人民医院,90后护士代尚在送病人回病房的电梯里,突然晕倒了,醒来后第一反应是问药有没有摔坏,爬起来还坚持送病人回病房。(人民网)

1、24小时两起严重枪击案,特朗普下令降半旗致哀 从3日上午至4日凌晨,美国得克萨斯州和俄亥俄州接连发生大规模枪击案,共造成29人遇难,逾40人受伤。白宫当天发表总统公告,向两起枪击案遇难者家属表示哀悼,特朗普下令全美降半旗致哀5天。(@中国新闻网)
2、伊朗抓扣一艘伊拉克油轮 伊朗伊斯兰革命卫队近日在波斯湾抓扣了一艘涉嫌油品走私的伊拉克油轮。油轮上载有70万升走私油品。据报道,涉事船只已被转移至伊朗港口城市布什尔。(央视新闻)
长安剑500人剑友大群开群!
快来扫描下方二维码,加长安君好友,
入驻论剑长安!位置有限!先到先入!
长安君等你哦~

注:已加入长安剑剑友群的不建议重复加入。
还不知道这些事?快戳蓝字


